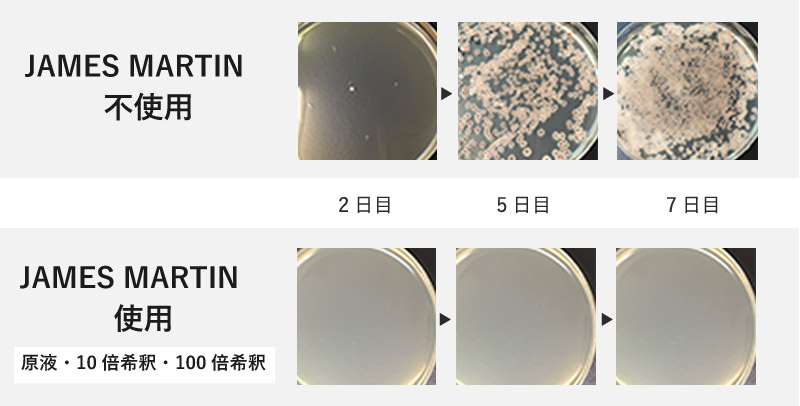

ジョエル・ロブションでも愛用
洗練された除菌アルコール
有名レストラン「ジョエル・ロブション」のキッチンでも愛用。洗練されたデザインとキッチン周りの衛生安全を兼ね備えた除菌用アルコール製剤「JAMES MARTIN(ジェームズマーティン)」です。除菌グッズとは思えない洗練されたデザインで、オフィスやお家でもスタイリッシュに置けるのが◎。
また食のプロフェッショナルな現場で使われるだけあり、その除菌効果もとても優秀。食中毒やインフルエンザのシーズンに衛生対策としてご使用いただけます。マスクに吹きかけたり、洗面台や調理器具の除菌など、食品成分のみを使用しているので日常シーンでも安心してお使いいただけます。
コチラは、洗面台や調理器具の除菌、マスクに吹きかけるのにも便利な、スプレーボトル 500mlです。


15秒で完了する除菌

シュシュっと吹きかけるだけで除菌完了。食中毒菌やウイルスへの不活性化効果試験でも、実証されているので安心です。
手やマスクの除菌、調理器具や洗面台周りの除菌など様々なシーンでお使いいただけます。
インフルエンザに対しての試験結果インフルエンザウイルスに対して使用した不活化効果試験において、使用15秒後にはインフルエンザウイルスは検出されませんでした。
ノロウィルスに対しての試験結果ネコカリシウイルス(ノロウイルスの代替ウイルス)に対して使用した抗ウイルス活性試験において、使用15秒後には99.99%の不活化が実証。
食中毒菌に対しての試験結果食中毒菌(O157/サルモネラ/黄色ブドウ球菌/腸炎ビブリオ)に対して使用した不活化効果試験において、使用15秒後にはこれら食中毒菌は検出されませんでした。
MRSAに対しての試験結果MRSA(メチシリン耐性黄色ブドウ球菌)に対して使用した不活化効果試験において、使用15秒後にはMRSAは検出されませんでした。
濡れた場所でも効果を発揮

一般的なアルコールは、濡れた場所(キッチンなど100%ドライではない環境下)では、除菌効果が著しく低下しますが、原液のままご使用頂き、濡れた場所に噴霧され6倍希釈が起こっても、除菌効果が実証されております。
弱酸性のバッファ効果(緩衝作用)により、水周りなど水滴のついた場所でも効果を発揮します。
※バッファ効果(緩衝作用)
DL-リンゴ酸、DL-リンゴ酸ナトリウムの配合により緩衝作用状態になり、加水されてもPH4.0以下を保ちます。ほとんどの食中毒菌はPH4以下になると増殖が止まります。
食品成分なので安心・安全

アルコールの除菌力にDL-リンゴ酸の弱酸性効果による除菌効果を添加。食品成分のみを使用した除菌用アルコール製剤なので、玄関・洗面所・キッチン周り・浴室などで安心してお使いいただけます。
また、アルコール濃度65v/vの非危険物アルコール製剤なので、保管も使用も消防法が適用されず、管理しやすいのも◎。
※医薬部外品の消毒薬には、イソプロピルメチルフェノールや塩化ベンザルコニウムなど殺菌消毒薬が含まれているものが多く、手指にもみ込んだ後、流水で洗い流す必要があります。(これら消毒薬(殺菌剤)は人体に有害です。)
気になる臭いにも

JAMES MARTINによる、消臭試験を実施したところ、アンモニア臭:99.7%、ノネナール(加齢臭):92.3%の消臭率が実証されました。お手洗いやペットのトイレ、枕などの寝具、スポーツシューズなどの除菌・消臭に効果が期待できます。
カビの発生を抑える、「抗カビ効果」を実証!

除菌・消臭に続き、第3の機能「抗カビ効果」が実証されました。クロカビ、アオカビに対し、原液・10倍希釈・100倍希釈の条件において実験したところ、発育しないという結果が得られています。
また、原液の状態に加えて、10倍希釈、100倍希釈のすべての条件下で試験を行ったことにより、浴室やキッチンなどで乾燥する前の水滴がついた状態でも変わらず、抗カビ効果があることが分かりました。
※実験内容:クロラムフェニコール入りポテトデキストロース培地(極東製薬工場(株)製)において、滅菌生成水で各希釈し、各条件に合わせた菌株接触後、平板培養法により35℃で7日間培養を行いました。
< 注意 >
※原液を薄めて使用することを想定しているのではなく、浴室や水回りなどで 乾燥する前に水滴のついた 状態にスプレーすることを想定しテストしています。
※衣類や家具などではアルコールによって損傷する素材もございます。対象物の注意書きを必ずご確認下さい。

安心・安全の日本製

日本の工場で、徹底した衛生管理のもと、製造しています。
白と黒で統一された洗練デザイン

白と黒で統一されたカラーと洗練された形状で、スタイリッシュに仕上げられたデザイン。ディッシュリキッド、薬用泡ハンドソープ、フレッシュサニタイザーをシンク周りに並べれば、モノトーンでまとまった統一感のあるキッチンに。